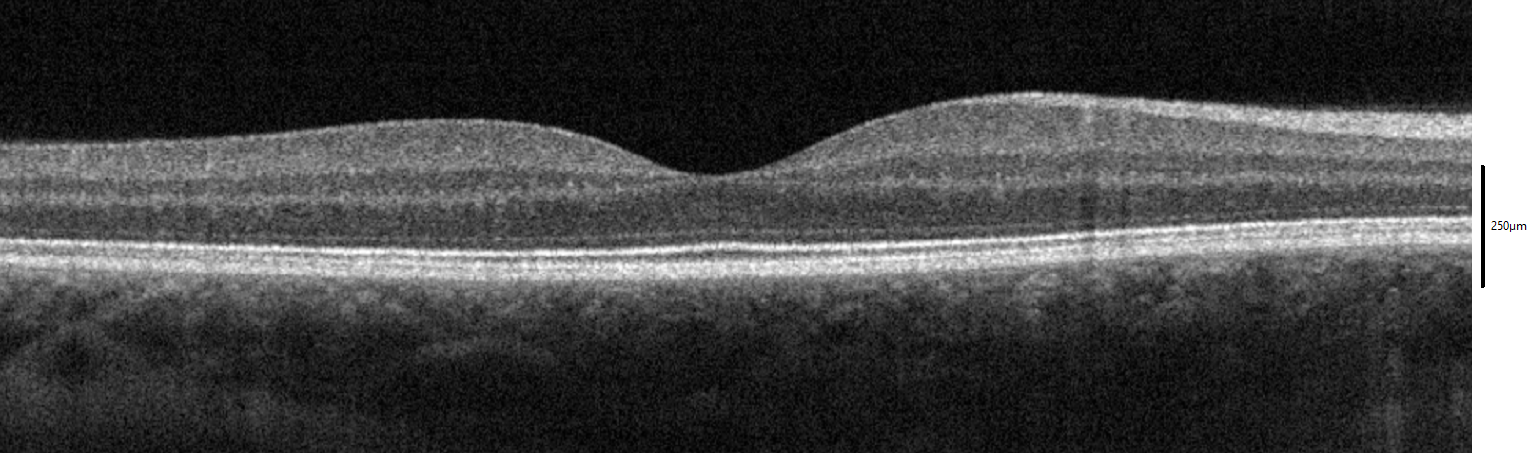

중심와
"오늘의AI위키"의 AI를 통해 더욱 풍부하고 폭넓은 지식 경험을 누리세요.
1. 개요
중심와는 망막의 중심부에 위치한 함몰 부위로, 시력을 담당하는 중요한 구조이다. 약 1.5mm의 너비로, 원뿔세포로만 구성되어 최대 시력을 제공하며, 중심와 무혈관 영역이 존재하여 빛의 분산을 최소화한다. 중심와 중심부에는 중심소(foveola)가 위치하며, 0.35mm 크기로 원뿔세포만 존재한다. 중심와는 시야의 중심 2도를 담당하며, 뇌의 시각 피질의 50% 이상을 차지한다. 중심와는 고해상도 시각을 위해 특화되어 있으며, 색각, 명시적 주의, 학습 등 다양한 시각 기능에 기여한다. 또한, 황반 색소인 루테인과 제아잔틴의 농도가 높아 청색광으로부터 보호하며, 맥스웰의 반점과 같은 특징을 보인다. 중심와는 영장류, 일부 물고기, 파충류, 조류에서 발견되며, 동물에 따라 형태가 다르다.
더 읽어볼만한 페이지
| 중심와 |
|---|
2. 구조
중심와는 망막 내부 표면의 함몰 부위로, 지름은 약 1.5mm이다. 광수용체층은 전부 원뿔세포로 구성되어 있으며, 최대 시력을 위해 특화되어 있다. 중심와는 시축상에 위치하지 않고, 4~8도 측두측에 있다. 시야의 중심 2도의 영역이며, 이는 팔을 뻗었을 때 엄지 손가락 폭의 2배 정도 크기이다.[40]
중심와는 영역으로 따지면 망막의 1%에도 미치지 못하지만, 뇌의 시각 피질에서의 면적은 50% 이상을 차지한다.[39]
270px
중심와는 크산토필이라는 노란색 색소로 덮여 있으며[36], 카로티노이드인 제아잔틴 및 루테인을 동반한다. 이는 원추 세포의 축삭인 헨레 섬유층에 존재한다.[36] 색소 영역은 청색을 흡수하는데, 이는 색수차로 인한 문제에 적응하는 진화적 의미가 있었을 것으로 추정된다.
인간의 중심와에서는 광수용체에 대한 망막 신경절 세포의 비율이 2.5 대 1에 가깝다. 즉, 대부분의 광수용체는 자신의 정보를 전달하는 전용 신경절 세포를 가지고 있어, 감각 데이터의 손실이 거의 발생하지 않으며, 고정밀의 시지각을 얻을 수 있게 된다.[38]
중심와는 색각에서 중요한 역할을 한다. 원추 세포는 색소인 옵신을 가지고 있으며, 이것이 색각을 가능하게 하기 때문이다.
중심와는 간상 세포가 존재하지 않으므로 저광량에 대한 감도를 갖지 못한다. 따라서 천문학자가 어두운 별을 관측할 때에는 시야의 중심에서 약간 벗어난 부분으로 보는 주시 회피를 사용하여 별을 더 잘 볼 수 있도록 한다.
중심와는 어류, 파충류, 조류에도 존재한다. 포유류 중에서는 진원류의 영장류만이 중심와를 가진다. 중심와는 생물 종에 따라 다른 형태를 갖는데, 예를 들어 영장류에서는 원추 세포가 중심와의 바닥에 위치하며, 얕은 층에 있는 다른 위치의 세포는 중심와에서 밀려나듯이 바깥쪽으로 이동한다. 이는 발생 초기 및 출생 직후에 발생한다. 다른 종에서는 내세포층의 두께 감소가 거의 없는 경우도 있다.
2. 1. 중심와 무혈관 영역
중심와 내에는 중심와 무혈관 영역(혈관이 없는 영역)이라고 하는 지름 0.5mm의 영역이 있어, 빛이 분산되거나 손실 없이 감지될 수 있다.[5] 이러한 해부학적 구조 덕분에 중심와는 함몰된 형태를 띤다. 중심와는 작은 무혈관 영역에 위치하며, 망막 색소 상피와 브루크막을 거쳐 맥락막의 혈관으로부터 대부분의 산소를 공급받는다. 혈관이 없고 원뿔세포의 밀도가 높은 점이 중심와에서 높은 시력을 가능하게 하는 요인이다.[6]2. 2. 중심와 오목부와 가장자리
중심와 오목부는 오목부에서 밀려난 뉴런을 포함하는 중심와 가장자리로 둘러싸여 있으며, 망막에서 가장 두꺼운 부분이다.[5]2. 3. 중심소 (Foveola)
중심와 중심부는 중심소(foveola)로, 지름 약 0.35mm이며, 원뿔세포 광수용체만 존재하고 사실상 막대세포는 없다.[1] 중심소의 원뿔세포는 매우 빽빽하고 얇으며, 육각형 패턴으로 배열되어 있다. 중심와 외곽에서부터 막대세포가 점차 나타나기 시작하고, 원뿔세포의 절대 밀도는 점진적으로 감소한다.2018년에 중심소의 해부학적 구조가 재조사되었으며, 원숭이의 중심 중심와 원뿔세포의 외부 세그먼트는 일자가 아니고 주변 중심와 (parafovea)의 외부 세그먼트보다 두 배 길다는 사실이 밝혀졌다.[7]
망막의 다른 영역과 비교하면, 중심와의 원추 세포는 직경이 작고, 더 밀집되어 있다(육각형 모양의 패턴을 만들고 있다).[36]
2. 4. 크기
황반은 망막의 다른 부분에 비해 비교적 크기가 작다. 그러나 이곳은 20/20 시력을 얻을 수 있는 망막의 유일한 영역이며, 미세한 부분과 색상을 구별할 수 있는 영역이다.[8][9]| 해부학적 구조 | 설명 | 직경 | 기타 |
|---|---|---|---|
| 황반 (macula lutea) / 중심 부위 (area centralis) (임상: 후극) | 5.5mm (~3.5 시신경 유두 직경) (약 18도의 VF) | ||
| 주황반 | 주와 (2.5mm)와 황반 가장자리 사이의 영역 | ||
| 주와 | 2.5mm | GCL은 5개 이상의 세포층을 가지며 원추 세포의 밀도가 가장 높음 | |
| 중심와 (fovea centralis) (임상: 황반) | 황반의 중심에 있는 함몰 부위 | 1.5mm (~1 시신경 유두 직경) (약 5도의 VF) | |
| 무혈관와 (FAZ) | 0.5mm (약 1.5도의 VF) | 소와와 거의 동일 | |
| 소와 (임상: 중심와) | 중심와의 중심 함몰 부위 | 0.35mm (약 1도의 VF) | |
| 융기 | 황반의 정확한 중심을 나타냄[10] | 0.15mm | 임상적인 빛 반사에 해당함 |
중심와는 정확한 시각을 담당하며, 시야의 중심 2도(팔 길이에서 손톱 너비의 약 2배)를 차지한다.[14][15] 망막 면적의 1% 미만을 차지하지만, 뇌의 시각 피질에서는 50% 이상을 차지할 정도로 중요한 영역이다.[13]
3. 해부학적 특징
해부학적 구조 설명 직경 기타 황반
(macula lutea)
중심 부위(area centralis)
(임상: 후극)5.5mm
(시신경 유두 직경의 약 3.5배)
(약 18도의 VF)주황반 주와 (2.5mm)와 황반 가장자리 사이의 영역.
GCL은 2~4개의 세포층.
100 µm 당 12개의 원추 세포.주와 GCL은 5개 이상의 세포층을 가지며 원추 세포의 밀도가 가장 높음. 2.5mm 중심와
(fovea centralis)
(임상: 황반)황반의 중심에 있는 함몰 부위. 1.5mm
(시신경 유두 직경의 약 1배)
(약 5도의 VF)무혈관와 (FAZ) 소와와 거의 동일. 0.5mm
(약 1.5도의 VF)소와
(임상: 중심와)중심와의 중심 함몰 부위.
100 µm 당 50개의 원추 세포.
가장 높은 시력.0.35mm
(약 1도의 VF)융기 황반의 정확한 중심.[10] 임상적인 빛 반사에 해당. 0.15mm
4. 기능

중심와에는 간상 세포가 없어 희미한 빛에는 민감하지 않다. 그래서 천문학자들은 희미한 별을 관측할 때 빗겨 시야를 사용한다.[36]
또한, 중심와는 황색 카로티노이드 색소인 루테인과 제아잔틴이 많이 분포되어 있다.[23][24] 이 색소들은 ''헨레 섬유층''(중심와에서 방사상으로 뻗어 나가는 광수용체 축삭)에 주로 분포하며, 고강도의 청색광으로부터 원추 세포를 보호하고, 색수차를 줄여 시력의 선명도를 높이는 역할을 한다.[25] 중심와 중심부에는 청색 원추 세포 밀도가 낮고, 청색 원추 세포의 최대 밀도는 중심와 주변의 고리에서 발생한다. 결과적으로 청색광에 대한 최대 예리함은 다른 색상보다 낮고 중심에서 약 1° 떨어진 곳에서 발생한다.[26]
4. 1. 신경절 세포와 광수용체 세포의 비율
영장류(인간 포함)의 중심와에서 망막 신경절 세포와 광수용체 세포의 비율은 약 2.5:1이다. 거의 모든 신경절 세포는 하나의 원추세포로부터 데이터를 수신하며, 각 원추세포는 1개에서 3개의 신경절 세포로 정보를 전달한다.[11]
4. 2. 명시적 주의와 중심와 고정
영장류(인간 포함)의 중심와에서 망막 신경절 세포와 광수용체 세포의 비율은 약 2.5:1이다. 거의 모든 신경절 세포는 하나의 원추 세포로부터 데이터를 수신하며, 각 원추 세포는 1개에서 3개의 신경절 세포로 정보를 전달한다.[11] 따라서 중심와 시력의 예리함은 원추 세포 모자이크의 밀도에 의해서만 제한되며, 중심와는 미세한 세부 사항에 가장 높은 감도를 가진 눈의 영역이다.[12] 중심와 중앙의 원추 세포는 녹색과 적색광에 민감한 옵신을 발현한다. 이러한 원추 세포는 중심와의 고해상도 기능을 뒷받침하는 '왜소' 경로이다.
중심와는 시선을 향하는 방향의 정확한 시각에 사용된다. 망막 크기의 1% 미만을 차지하지만 뇌의 시각 피질의 50% 이상을 차지한다.[13] 중심와는 시야의 중심 2도만 볼 수 있다(팔 길이에서 손톱 너비의 약 2배).[14][15] 객체가 크고 따라서 큰 각도를 덮는 경우, 눈은 지속적으로 시선을 이동하여 이미지를 중심와로 가져와야 한다(독서 시 안구 운동과 같이). 중심와 고정은 가장 관련성이 높은 정보 소스에 감각 처리 리소스를 집중할 수 있게 해주는 명시적 주의의 한 형태로 간주된다.[16][17][18][19] 또한, 중심와 시각은 관련 없는 맥락을 무시하고 관련 정보에만 낮은 차원으로 집중함으로써 특정 시각 작업의 학습을 가속화할 수 있다.[20][21]
4. 3. 중심와 시각과 학습
영장류(인간 포함)의 망막 신경절 세포와 광수용체 세포의 비율은 약 2.5:1이다. 거의 모든 신경절 세포는 하나의 원추 세포로부터 데이터를 수신하며, 각 원추 세포는 1개에서 3개의 신경절 세포로 정보를 전달한다.[11] 따라서 중심와 시력의 예리함은 원추 세포 모자이크의 밀도에 의해서만 제한되며, 중심와는 미세한 세부 사항에 가장 높은 감도를 가진 눈의 영역이다.[12] 중심와 중앙의 원추 세포는 녹색과 적색광에 민감한 옵신을 발현한다. 이러한 원추 세포는 중심와의 고해상도 기능을 뒷받침하는 '왜소' 경로이다.
중심와는 시선을 향하는 방향의 정확한 시각에 사용된다. 망막 크기의 1% 미만을 차지하지만 뇌의 시각 피질의 50% 이상을 차지한다.[13] 중심와는 시야의 중심 2도만 볼 수 있다(팔 길이에서 손톱 너비의 약 2배).[14][15] 객체가 크고 따라서 큰 각도를 덮는 경우, 눈은 지속적으로 시선을 이동하여 이미지를 중심와로 가져와야 한다(독서 시 안구 운동과 같이). 중심와 고정은 또한 가장 관련성이 높은 정보 소스에 감각 처리 리소스를 집중할 수 있게 해주는 명시적 주의의 한 형태로 간주된다.[16][17][18][19] 또한, 중심와 시각은 관련 없는 맥락을 무시하고 관련 정보에만 낮은 차원으로 집중함으로써 특정 시각 작업의 학습을 가속화할 수 있다.[20][21]
중심와에는 막대 세포가 없으므로 희미한 조명에 민감하지 않다. 따라서 희미한 별을 관찰하기 위해 천문학자들은 막대 세포의 밀도가 더 높은 눈의 옆을 보며 빗겨 시야를 사용하며, 따라서 희미한 물체를 더 쉽게 볼 수 있다.
중심와는 황색 카로티노이드 색소인 루테인과 제아잔틴의 농도가 높다. 이들은 ''Henle 섬유층''(중심와에서 방사상으로 뻗어 나가는 광수용체 축삭)과 원추 세포에 덜 농축되어 있다.[23][24] 이들은 고강도의 청색광의 영향으로부터 보호 역할을 하는 것으로 여겨지며, 이는 민감한 원추 세포를 손상시킬 수 있다. 또한, 이 색소는 중심와의 단파장에 대한 감도를 줄이고 색수차의 영향을 상쇄하여 중심와의 예리함을 향상시킨다.[25] 이는 또한 중심와 중심부의 청색 원추 세포 밀도가 낮아지는 현상과 동반된다.[26] 청색 원추 세포의 최대 밀도는 중심와 주변의 고리에서 발생한다. 결과적으로 청색광에 대한 최대 예리함은 다른 색상보다 낮고 중심에서 약 1° 떨어진 곳에서 발생한다.[26]
4. 4. 빗겨 시야 (Averted Vision)
중심와에는 막대 세포가 없으므로 희미한 조명에 민감하지 않다. 따라서 희미한 별을 관찰하기 위해 천문학자들은 막대 세포의 밀도가 더 높은 눈의 옆을 보며 빗겨 시야를 사용하며, 희미한 물체를 더 쉽게 볼 수 있도록 한다.[36]
4. 5. 황반 색소
중심와는 황색 카로티노이드 색소인 루테인과 제아잔틴의 농도가 높다.[23][24][36] 이들은 ''Henle 섬유층''(중심와에서 방사상으로 뻗어 나가는 광수용체 축삭)과 원추 세포에 덜 농축되어 있다.[23][24] 이 색소들은 고강도의 청색광으로부터 원추 세포를 보호하고, 색수차의 영향을 상쇄하여 중심와의 예리함을 향상시킨다.[25] 이는 중심와 중심부의 청색 원추 세포 밀도가 낮아지는 현상과 함께 나타난다.[26] 청색 원추 세포의 최대 밀도는 중심와 주변의 고리에서 발생하며, 결과적으로 청색광에 대한 최대 예리함은 다른 색상보다 낮고 중심에서 약 1° 떨어진 곳에서 발생한다.[26]
4. 6. 맥스웰의 반점 (Maxwell's Spot)
영장류(인간 포함)의 중심와에는 황색 카로티노이드 색소인 루테인과 제아잔틴이 많이 들어있다. 이 색소들은 ''헨레 섬유층''(중심와에서 방사상으로 뻗어 나가는 광수용체 축삭)에 주로 분포하며, 고강도의 청색광으로부터 원추 세포를 보호하고, 색수차를 줄여 시력의 선명도를 높이는 역할을 한다.[25]
중심와는 파란색 원추 세포의 밀도가 낮고, 황반 색소와 단파장 원추 세포의 분포가 결합되어 파란색 빛에 대한 감도가 낮다.[26] 이러한 특성 때문에 일반적인 상황에서는 파란색 빛 암점이 인지되지 않지만, 특정 조건의 파란색 빛 아래에서는 어두운 점이 나타나는데, 이를 '''맥스웰의 반점'''이라고 한다.[31] 맥스웰의 반점은 빨간색과 파란색 빛이 혼합된 빛을 볼 때도 나타나며, 이 경우 중심부에 빨간색 점이 보이고 그 주위를 몇 개의 빨간색 테두리가 둘러싸는 형태로 나타난다.[31][32] 이 현상은 제임스 클러크 맥스웰[33]에 의해 발견되었다.
헨레 섬유층의 방사형 축삭에 존재하는 색소는 이색성과 복굴절[30] 특성을 가져 파란색 빛에 영향을 준다. 이 효과는 하이딩거 브러시를 통해 확인할 수 있다.
5. 중심와 원뿔 세포의 각 크기
평균적으로 중심와 1제곱밀리미터(mm²)에는 약 147,000개의 원뿔 세포가 있다.[27] 눈의 평균 초점 거리(수정체와 중심와 사이의 거리)는 17.1mm이며,[28] 이를 통해 계산된 단일 원뿔 세포의 평균 시야각은 대략 31.5 각초이다.
최대 원뿔 세포 밀도는 개인에 따라 100,000개/mm² 미만에서 324,000개/mm² 초과까지 다양하게 나타난다.[29] 높은 원뿔 밀도와 완벽한 광학 조건을 갖춘 사람은 21.2 각초 크기의 픽셀까지 구별할 수 있다.
시력이 20/20인 사람은 60각초 미만의 픽셀을 볼 수 없다. 31.5 각초와 21.2 각초 크기의 픽셀을 구분하려면 각각 20/10.5와 20/7.1의 시력이 필요하다.
6. 양안 시와 비정상 망막 대응
양안 시에서 두 눈은 양안 시각을 가능하게 하기 위해 수렴하며, 이는 높은 입체 시력을 얻는 데 필수적이다.
반면, 비정상 망막 대응으로 알려진 상태에서는 뇌가 한쪽 눈의 중심와를 다른 쪽 눈의 중심외 영역과 연결한다.
7. 다른 동물에서의 중심와
중심와는 여러 종류의 물고기, 파충류, 조류의 망막 표면에 있는 함몰부이기도 하다. 포유류 중에서는 원숭이 영장류에서만 발견된다. 망막 중심와는 동물의 종류에 따라 약간 다른 형태를 취한다. 예를 들어, 영장류의 경우 원추 광수용체가 중심와 함몰부의 기저를 이루고 있으며, 망막의 다른 부분에서 더 얕은 층을 형성하는 세포들은 후기 태아 및 초기 출생 후 시기에 중심와 영역에서 멀리 이동하게 된다. 다른 중심와는 거의 완전한 부재보다는 내부 세포 층의 두께가 감소된 형태로 나타날 수 있다.
대부분의 조류는 단일 중심와를 가지고 있지만, 매, 제비, 벌새는 이중 중심와를 가지고 있다. 두 번째 중심와는 측두 중심와라고 불리며, 느린 움직임을 추적할 수 있게 해준다.[34] 전형적인 조류 중심와 내 원추 세포의 밀도는 1제곱밀리미터당 400,000개이지만, 일부 조류는 1제곱밀리미터당 1,000,000개에 달하는 밀도를 보일 수 있다(예: 붉은발말똥가리).[35]
참조
[1]
웹사이트
Simple Anatomy of the Retina
http://webvision.med[...]
University of Utah
2011-09-28
[2]
논문
Relation between superficial capillaries and foveal structures in the human retina
http://iovs.arvojour[...]
[3]
문서
eye, human.
Encyclopædia Britannica
2008
[4]
논문
Carl Bergmann (1814–1865) and the discovery of the anatomical site in the retina where vision is initiated
https://www.tandfonl[...]
2023-12-18
[5]
서적
Vaughan & Asbury's general ophthalmology
McGraw-Hill Medical
[6]
논문
Adaptation of the central retina for high acuity vision: Cones, the fovea and the avascular zone
[7]
논문
The anatomy of the foveola reinvestigated
[8]
웹사이트
Age-Related Macular Degeneration (AMD)
http://webvision.med[...]
2013-12-11
[9]
웹사이트
Macular Degeneration Frequently Asked Questions
http://www.eyesight.[...]
2013-12-11
[10]
간행물
Ophthalmology
Elsevier Saunders
[11]
논문
Cell density ratios in a foveal patch in macaque retina
http://retina.anatom[...]
[12]
간행물
Light:Student Guide and Source Book.
Carolina Biological Supply Company
[13]
서적
Experiencing Sensation and Perception
http://psych.hanover[...]
Pearson Education
2012-04-06
[14]
서적
Color Appearance Models
Addison, Wesley, & Longman
[15]
문서
Thumb’s rule tested: Visual angle of thumb’s width is about 2 deg.
https://doi.org/10.1[...]
[16]
간행물
Methods
http://dx.doi.org/10[...]
Springer US
1967
[17]
논문
State-of-the-Art in Visual Attention Modeling
http://dx.doi.org/10[...]
2013
[18]
논문
Eye guidance in natural vision: Reinterpreting salience
http://dx.doi.org/10[...]
2011-05-27
[19]
논문
The where, what and when of gaze allocation in the lab and the natural environment
2011
[20]
논문
Eye-Hand Coordination during Learning of a Novel Visuomotor Task
http://dx.doi.org/10[...]
2005-09-28
[21]
논문
Ecological Active Vision: Four Bioinspired Principles to Integrate Bottom–Up and Adaptive Top–Down Attention Tested With a Simple Camera-Arm Robot
2014
[22]
웹사이트
Foundations of Vision
https://stanford.edu[...]
2013-12-03
[23]
논문
Biologic Mechanisms of the Protective Role of Lutein and Zeaxanthin in the Eye
[24]
논문
Lutein, Zeaxanthin, and the Macular Pigment
[25]
논문
Macular pigment and age related macular degeneration
[26]
논문
Distribution and morphology of human cone photoreceptors stained with anti-blue opsin
[27]
서적
An Eye on Numbers: A Ready Reckoner in Ophthalmology
https://books.google[...]
Postscript Media Pvt
[28]
서적
Optical Processes in Microparticles and Nanostructures: A Festschrift Dedicated to Richard Kounai Chang on His Retirement from Yale University
https://books.google[...]
World Scientific
[29]
논문
Human photoreceptor topography
[30]
논문
Determination of foveal location using scanning laser polarimetry
[31]
논문
Filling-in of the foveal blue scotoma
[32]
논문
Functional Structure of the Retinal Fovea and Maxwell's Spot
[33]
논문
Centricity of Maxwell's Spot in Strabismus and Amblyopia
[34]
웹사이트
Birds Comparative Physiology of Vision
http://archives.ever[...]
2019-12-29
[35]
웹사이트
Avian Eye Tunics
https://campus.murra[...]
2019-12-29
[36]
웹사이트
Simple Anatomy of the Retina
http://webvision.med[...]
University of Utah, Webvision: The Organization of the Retina and Visual System
2005-09
[37]
간행물
Relation Between Superficial Capillaries and Foveal Structures in the Human Retina
http://www.iovs.org/[...]
1986
[38]
서적
Light:Student guide and Source Book
Smithsonian/The National Academies, Carolina Biological Supply Company
2002
[39]
웹사이트
The Stimulus and Anatomy of the Visual System
https://web.archive.[...]
Hanover College, Psychology Department
[40]
서적
Color Appearance Models
Addison, Wesley, & Longman
1998
본 사이트는 AI가 위키백과와 뉴스 기사,정부 간행물,학술 논문등을 바탕으로 정보를 가공하여 제공하는 백과사전형 서비스입니다.
모든 문서는 AI에 의해 자동 생성되며, CC BY-SA 4.0 라이선스에 따라 이용할 수 있습니다.
하지만, 위키백과나 뉴스 기사 자체에 오류, 부정확한 정보, 또는 가짜 뉴스가 포함될 수 있으며, AI는 이러한 내용을 완벽하게 걸러내지 못할 수 있습니다.
따라서 제공되는 정보에 일부 오류나 편향이 있을 수 있으므로, 중요한 정보는 반드시 다른 출처를 통해 교차 검증하시기 바랍니다.
문의하기 : help@durumis.com

